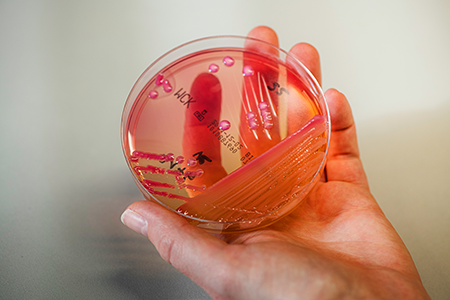
Biomed. Analytikerin runde Probe

Sie identifizieren Bakterien, Viren und Parasiten und stellen sorgfältig ausgetestetes Spendenblut bereit.
Ihre Laboranalysen sind ein wichtiger Beitrag an die Diagnose oder Überwachung einer medizinischen Behandlung und für die Resultate tragen sie die Verantwortung. Die Arbeit ist stark technisch geprägt. Knifflige Spezialuntersuchungen erfordern manuelles Geschick. Hochempfindliche Präzisionsapparate und computerisierte Messgeräte stehen neben Mikroskopen in jedem Labor. Biomedizinische Analytikerinnen und Analytiker arbeiten in verschiedenen Fachbereichen des medizinischen Labors wie beispielsweise Hämatologie/Hämostase, Histologie, Immunhämatologie, klinische Chemie, klinische Immunologie, medizinische Bakteriologie, Molekularbiologie oder klinische Zytologie.
Arbeitsfelder
Biomedizinische Analytikerinnen und Analytiker arbeiten vorwiegend in Spitälern, privaten Laboratorien und Universitätsinstituten. Sie sind mehrheitlich in der Diagnostik tätig und beteiligen sich an Forschungsprojekten.
Zum Beispiel Natascha Koldiajew, Biomedizinische Analytikerin
Natascha Koldiajew arbeitet im Labor eines mittelgrossen Spitals. Sie untersucht Blut, analysiert Proben von Urin, Stuhl, Sekreten sowie Gewebe, Glukose, Fettstoffe oder Proteine. Erste Priorität hat heute die Blutuntersuchung eines Patienten, der gestern mit einem Herzinfarkt eingeliefert wurde. Das Begleitformular zeigt ihr auf, welche Werte Natascha Koldiajew bestimmen muss – verlangt wird das Zählen weisser und roter Blutkörperchen. Dazu stehen der Medizinlaborantin modernste Geräte und Computer zur Verfügung. Natascha Koldiajew ist für die richtige Bedienung und die Auswertung der Resultate verantwortlich. Als Nächstes analysiert sie die Knochenmarkproben einer jungen Patientin, die wegen Gelenkschmerzen den Arzt aufsuchte. Unter dem Mikroskop unterscheidet sie die angefärbten Zellen nach verschiedenen Merkmalen und teilt sie in Kategorien ein. Dank dieser Untersuchung kann eine Krankheit im Anfangsstadium erkannt und behandelt werden.